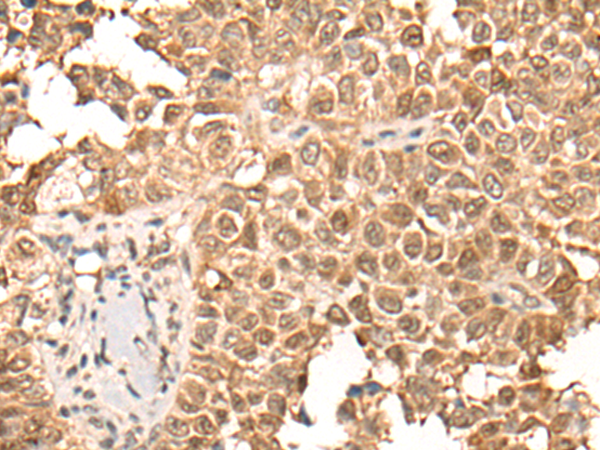

中文名稱(chēng): 兔抗CDCA5多克隆抗體
英文名稱(chēng): Anti-CDCA5 rabbit polyclonal antibody
抗 原: CDCA5
儲(chǔ) 存: 冷凍(-20℃)
宿 主: Rabbit
相關(guān)類(lèi)別: 一抗
反應(yīng)種屬: Human, Mouse
標(biāo) 記 物: Unconjugate
克隆類(lèi)型: rabbit polyclonal
|
Background: |
Regulator of sister chromatid cohesion in mitosis stabilizing cohesin complex association with chromatin. May antagonize the action of WAPL which stimulates cohesin dissociation from chromatin. Cohesion ensures that chromosome partitioning is accurate in both meiotic and mitotic cells and plays an important role in DNA repair. Required for efficient DNA double-stranded break repair. |
|
Applications: |
ELISA, IHC |
|
Name of antibody: |
CDCA5 |
|
Immunogen: |
Synthetic peptide of human CDCA5 |
|
Full name: |
cell division cycle associated 5 |
|
Synonyms: |
SORORIN |
|
SwissProt: |
Q96FF9 |
|
ELISA Recommended dilution: |
5000-10000 |
|
IHC positive control: |
Human ovarian cancer and human thyroid cancer |
|
IHC Recommend dilution: |
25-100 |

購(gòu)物車(chē)
購(gòu)物車(chē) 幫助
幫助
 021-54845833/15800441009
021-54845833/15800441009
